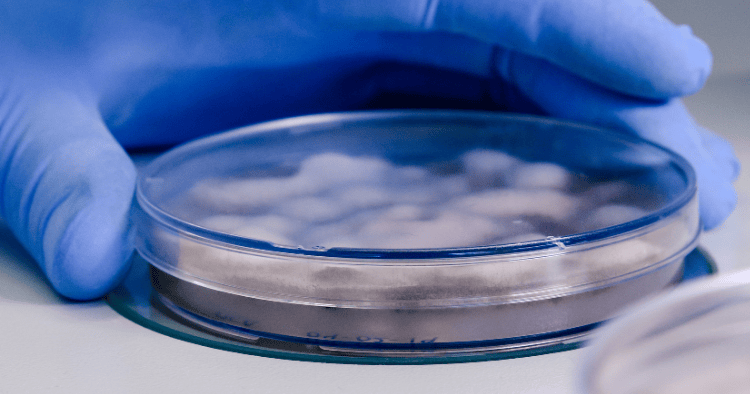

Steps to Properly Use a Microbial Count Plate for Microbial Analysis in Laboratories
Steps to Properly Use a Microbial Count Plate for Microbial Analysis in Laboratories For the detection and measurement of microorganisms in a variety of samples,
Steps to Properly Use a Microbial Count Plate for Microbial Analysis in Laboratories For the detection and measurement of microorganisms in a variety of samples,

Bacterial filters are vital in both home and commercial settings in the modern world, where it is imperative to maintain a clean and healthy atmosphere.

Ensuring clean air and water is more important than ever in the modern world. Bacterial filters are becoming essential in both home and commercial settings

When there are airborne risks at work, respirators are essential safety equipment. Workers’ health may be severely impacted by these dangerous gases and particles, which

Workers in numerous sectors are exposed to dangerous airborne pollutants such as dust, chemicals, fumes, and gases, which over time may have a major negative

Syringe filters are essential equipment for clinical and medical labs. These filters aid in removing impurities from materials that might compromise the procedure or the

A tiny, throwaway filter that fits on the end of a syringe is called a syringe filter. To make sure the material being utilised is

Zola Predosa (BO), December 3rd, 2024 GVS S.p.A., a global leader in advanced filtration solutions, has announced a binding agreement to acquire Haemonetics Corporation’s Transfusion

Microbial count plates, which offer rapid and accurate quantitative evaluations of microbial contamination, are crucial instruments in microbiological testing. At GVS Malaysia, we recognise that

It is crucial for GVS Malaysia to be on the cutting edge of respirator technology. We continuously improve the efficacy and comfort of our respirators

First patent for ‘Infusion device with air intake’ registered by GVS
Discover how EG TECH System Sdn Bhd can support your next construction project with our advanced aluminum formwork solutions. Contact us today to learn more about our products and services, or request a consultation with our expert team.
EG Tech System Sdn Bhd (1511216-P)
© 2025 EG Tech System. All rights reserved.
We are always here for you! send us a mail now if you have any questions!